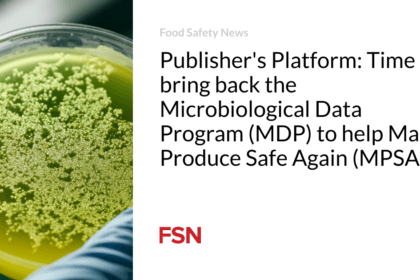
प्रकाशक का मंच: उत्पादन को फिर से सुरक्षित बनाने (एमपीएसए) में मदद के लिए माइक्रोबायोलॉजिकल डेटा प्रोग्राम (एमडीपी) को वापस लाने का समय आ गया है।

Focus on boosting agriculture and livestock production! | (कृषि एवं पशु उत्पादन वृद्धि पर ध्यान दें )
Main Points In Hindi (मुख्य बातें - हिंदी में) नगर पालिका मामलों…
Time to revive MDP for safer production with MPSA! | (प्रकाशक का मंच: उत्पादन को फिर से सुरक्षित बनाने (एमपीएसए) में मदद के लिए माइक्रोबायोलॉजिकल डेटा प्रोग्राम (एमडीपी) को वापस लाने का समय आ गया है। )
Main Points In Hindi (मुख्य बातें - हिंदी में) माइक्रोबायोलॉजिकल डेटा प्रोग्राम…
“Derrick Solano’s bold book challenges societal norms in agriculture!” | (बकवास परफेक्ट: डेरिक सोलानो की बोल्ड बोनस पुस्तक समाज के पूर्णता के विचार को चुनौती देती है – कृषि उद्योग आज )
Main Points In Hindi (मुख्य बातें - हिंदी में) पुस्तक का शीर्षक…
Labour Party steers clear of trade deal with Trump to calm farmers. | (उग्र किसानों को शांत करने के लिए लेबर पार्टी ट्रंप के साथ व्यापार समझौते से दूर रहने को तैयार है )
Main Points In Hindi (मुख्य बातें - हिंदी में) यहाँ "लेबर 'उग्र…
“Exploiting Nature’s Arsenal: Phospholipids in Plant Defense” | (प्रकृति के शस्त्रागार का दोहन: पौधों की रक्षा तंत्र में फॉस्फोलिपिड्स )
Main Points In Hindi (मुख्य बातें - हिंदी में) फसल रोगों का…
“Unlocking Africa’s economy with decentralized edge and quantum tech” | (अफ्रीका की आर्थिक क्षमता को अनलॉक करने के लिए विकेंद्रीकृत एज और क्वांटम कंप्यूटिंग का उपयोग करना )
Main Points In Hindi (मुख्य बातें - हिंदी में) यहां "हर्नेसिंग विकेंद्रीकृत…
“₹5.5 Lakh Fraud in Fake Insurance Refund Scheme in Kanpur” | (फर्जी बीमा पॉलिसी रिफंड योजना में कृषि विभाग के अधिकारी से ₹5.5 लाख की ठगी | कानपुर समाचार )
Main Points In Hindi (मुख्य बातें - हिंदी में) धोखाधड़ी की घटना:…
Agriculture Minister Shivraj Singh Chauhan reached Raisen tour in Vidisha, reviewed 14 schemes of the Centre. | (कृषि मंत्री शिवराज सिंह चौहान ने Raisen में 14 केंद्र योजनाओं की समीक्षा की।)
Main Points In Hindi (मुख्य बातें - हिंदी में) मुख्य बिंदु केंद्र…
Corn for ethanol raises poultry feed, cooking oil prices, alarming sugar and soybean farmers. | (इथेनॉल के लिए मक्के के उपयोग से पोल्ट्री फ़ीड, खाद्य तेल की कीमतें बढ़ जाती हैं, जिससे चीनी उद्योग, सोयाबीन किसानों के लिए चिंताएं बढ़ जाती हैं )
Main Points In Hindi (मुख्य बातें - हिंदी में) इथेनॉल उत्पादन में…
“Access Denied: Entry Request Rejected!” | (पहुंच अस्वीकृत )
Main Points In Hindi (मुख्य बातें - हिंदी में) यहां "पहुंच अस्वीकृत"…
“Unlocking Africa’s economy with decentralized edge and quantum tech.” | (अफ्रीका की आर्थिक क्षमता को अनलॉक करने के लिए विकेंद्रीकृत एज और क्वांटम कंप्यूटिंग का उपयोग करना )
Main Points In Hindi (मुख्य बातें - हिंदी में) Here are 3…
Researchers innovate solar-powered dairy machine for agri-revolution! | (शोधकर्ताओं ने सौर ऊर्जा से संचालित गाय-दूध देने वाला उपकरण विकसित किया है जो कृषि उद्योग को बदल सकता है: ‘नवाचार को अपनाएं’ )
Main Points In Hindi (मुख्य बातें - हिंदी में) सौर-संचालित उपकरण: लिलोंग्वे…